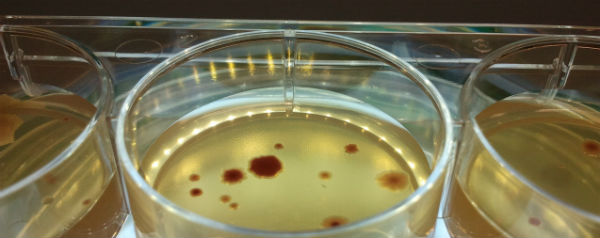

Bacteriën die alleen zijn, muteren eerder. Hierdoor hebben ze een grotere kans om weerstand te bieden aan antibiotica.
Wetenschappers van de Universiteit van Manchester deden deze opvallende ontdekking toen ze het mutatiegedrag van de E. coli-bacterie aan het bestuderen waren. Ze zochten naar een verband tussen de omgeving waarin de bacterie leefde en het aantal mutaties. En daaruit bleek: hoe eenzamer de bacterie, hoe meer hij muteert en hoe resistenter hij wordt tegen antibiotica.
Communicatie tussen bacteriën
Maar hoe weet een bacterie eigenlijk dat hij eenzaam is? Dit kan door het zogenoemde quorum sensing; een soort communicatiemiddel tussen bacteriën. De eencelligen sturen signaalmoleculen naar elkaar toe om aan te geven wanneer de omgeving verandert. Als ze merken dat deze communicatie vermindert, weten ze dat er minder soortgenoten in de omgeving zijn en dat er waarschijnlijk gevaar nadert. Om zich hiertegen te beschermen, gaan de bacteriën meer muteren, zodat hun overlevingskansen groter worden.
Het onderzoeksteam hoopt nu een techniek te vinden om deze quorum sensing te kunnen sturen en zo de antibioticaresistentie te minimaliseren. Dit is belangrijk onderzoek, omdat deze resistentie behoorlijk uit de hand begint te lopen en we uiteraard niet terug willen naar een tijd waarin elke infectie levensbedreigend was.
In KIJK 6/2014, die vanaf morgen in de winkel ligt, lees je meer over hoe erg de dreiging nu precies is en wat we ertegen kunnen doen. Op de site alvast een voorproefje.
Bronnen: Nature Communications, Wellcome Trust via EurekAlert!
Tekst: Tom Gerrits
Beeld: Rok Krašovec/Universiteit van Manchester